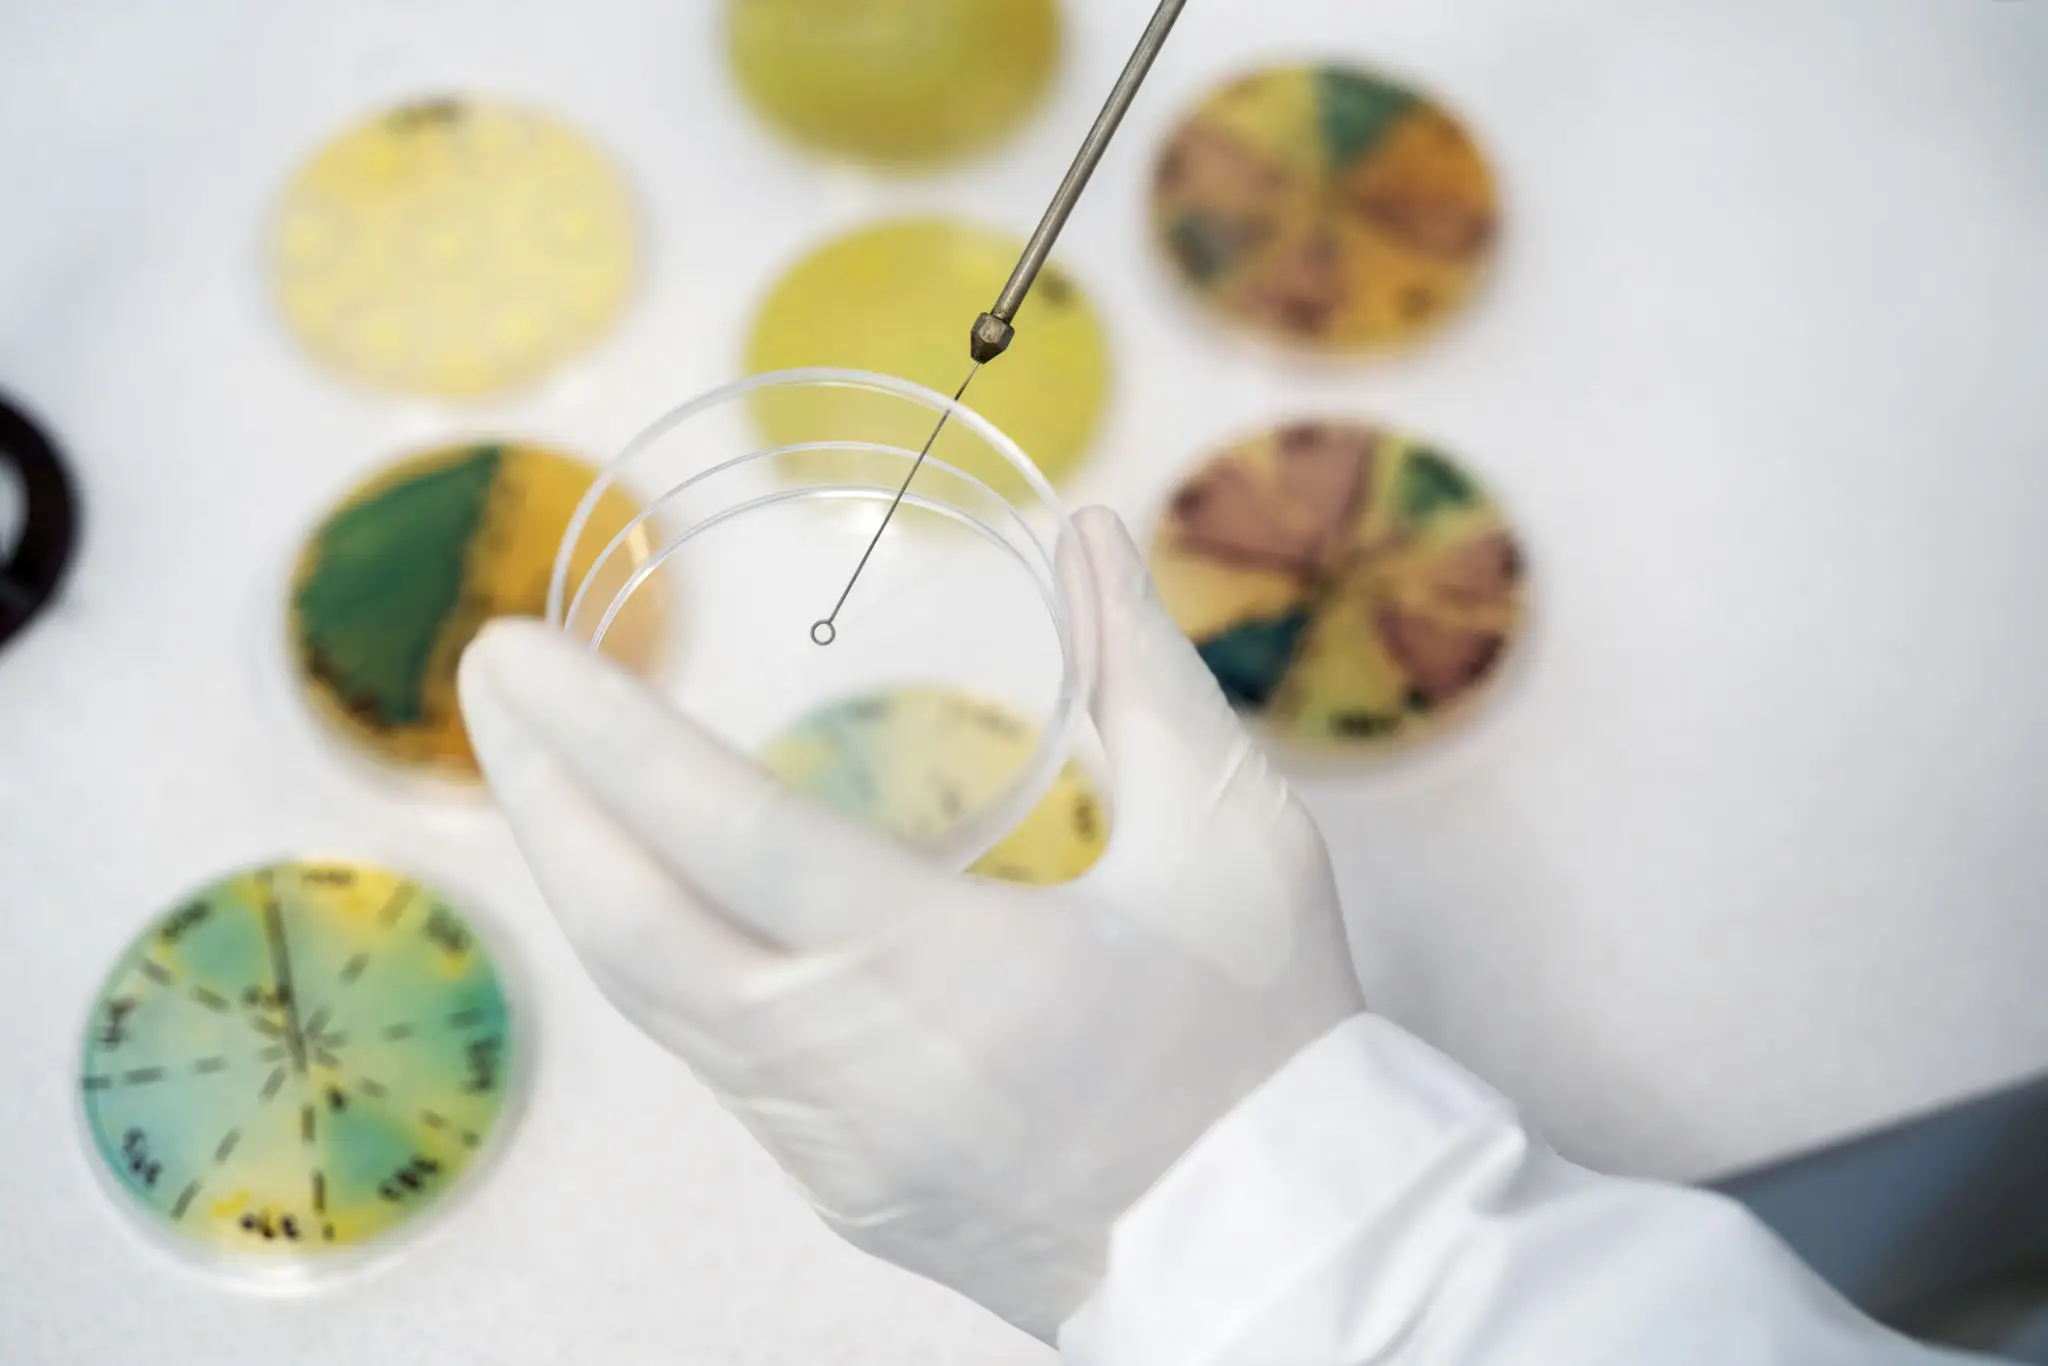

Tu salud en manos expertas
Conoce más sobre nuestro equipo y la tecnología que nos respalda.
Sobre Nosotros – Laboratorios Valdés
Nuestro Enfoque
Laboratorio Valdés, fundado en 1969 por LCB. Benjamín Valdez Salinas y LCB. Ma. Elena Juárez de Valdez, cuenta con más de 50 años de experiencia en análisis clínicos. Desde sus inicios, nuestra misión ha sido ofrecer servicios de laboratorio confiables y personalizados, con una comunicación clara que garantice diagnósticos precisos y oportunos.
En el año 2000, el laboratorio se expandió con la creación del área L-2, especializada en bacteriología clínica y microbiología sanitaria de agua y alimentos. Ese mismo año, se incorporó al equipo el QFB. Alan Eduardo Valdez Juárez, quien lideró la implementación de un sistema de gestión de calidad.
En 2009, se creó el área L-3, dedicada exclusivamente a la microbiología sanitaria, autorizada por la Secretaría de Salud y reconocida por COFEPRIS. Esto nos permitió brindar apoyo a las jurisdicciones sanitarias de la región y a la industria restaurantera, con análisis confiables y avalados a nivel nacional.
Hoy en día, Laboratorio Valdés continúa fortaleciendo su sistema de calidad, garantizando excelencia, confiabilidad y confianza en cada uno de sus servicios.About Us – Laboratorios Valdés
Misión
En Laboratorios Valdés, estamos comprometidos en ofrecer análisis clínicos precisos y confiables, apoyando la salud de nuestros pacientes a través de servicios de laboratorio de la más alta calidad.

Visión
Ser el laboratorio de referencia en la región, reconocido por su exactitud, rapidez y calidez humana en cada resultado.
Conoce más
Pruebas clínicas que realizamos
Estudios Área Médica
Explora nuestras pruebas especializadas organizadas por disciplina médica. Cada área cubre estudios específicos que ayudan a diagnosticar, prevenir y controlar diferentes condiciones de salud, brindando una visión integral para tu bienestar.
Estudios de Organos
Descubre estudios diseñados para evaluar la función y salud de órganos clave del cuerpo. Estos análisis permiten detectar alteraciones tempranas, prevenir complicaciones y orientar tratamientos personalizados.
Estudios de enfermedades
Accede a pruebas específicas relacionadas con diversas enfermedades y condiciones. Estas pruebas ayudan a detectar, controlar y prevenir complicaciones, ofreciendo diagnósticos precisos y apoyo para tu salud continua.
¡Ponte en contacto con nosotros!
Comunícate con nosotros usando el formulario de consulta o los datos de contacto que aparecen a continuación.
© 2025 Created with LabvaldesMKT